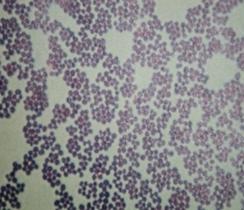

| CATEGORII DOCUMENTE |
| Demografie | Ecologie mediu | Geologie | Hidrologie | Meteorologie |
CRESTEREA EFICENTEI EPURARII APELOR UZATE ORASENESTI PRIN "TREPTA BIOLOGICA" SAU EPURAREA CU NAMOL ACTIV
1. CONSIDERATII GENERALE ASUPRA PROCESULUI DE EPURARE
BIOLOGICA.
Epurarea biologica a apelor uzate constituie un procedeu de tratare a apelor de canalizare bazate pe fenomene biochimice ce decurg din metabolismul microorganismelor ce populeaza apa uzata si are ca scop retinerea din aceste ape a suspensiilor coloidale sau dizolvate de natura organica. Epurarea biologica este o ramura a biotehnologiei, adica a acelei combinatii intre biologie si tehnologie prin care procesele biologice sunt conduse cu procedee tehnice adecvate incat, concordanta dintre reactiile microorganismelor si apa uzata sa conduca la obtinerea unei ape epurate lipsita practic total de substante organice asimilabile.
De aici putem concluziona importanta primordiala a epurarii biologice in procesul de epurare a apelor uzate orasenesti.
Indepartarea poluantilor de natura organica biodegradabila din apele uzate prin procese biologice se produce fie prin fenomenul natural de autoepurare, intalnit la apele de suprafata, fie prin epurarea biologica intensiva, in statia de epurare. Epurarea biologica se realizeaza fie in instalatii de epurare naturala ( iazuri biologice, campuri de irigare, etc ) fie in instalatii de epurare artificiala ( filtre biologice, bazine de aerarecu namol activ, biodiscuri, bazine de fermentare anaeroba de contact, etc ) , in care au loc acele fenomene biochimice, cu ajutorul microorganismelor care mineralizeaza partial substantele organice pe baza de carbon, transformandu-le in material celular ( biomasa ) care se retine sub forma de namol activ in decantoarele secundare.
Posibilitatea degradarii biologice a materiei organice din apa uzata este indicata de raportul CBO5/CCO care nu trebuie sa fie mai mic de 0,3.
Pentru o buna desfasurare a proceselor biologice de epurare este esentiala si existenta nutrientilor, in principal compusi de fosfor si azot.
Procedeele de epurare biologica utilizeaza una din cele duoa grupe, fiziologic diferite, de microorganisme : aerobe sau anaerobe. Microorganismele anaerobe se folosesc pentru fermentarea namolurilor si pentru fermentarea unor ape industriale concentrate. Microorganismele aerobe sunt folosite in mod curent la epurarea majoritatii apelor uzate cu caracter predominant organic si, in ultima vreme, la fermentarea aeroba a namolurilor.
Desi procedeele aerobe de epurare biologica sunt foarte diferite, cu privire la timpul de contact intre microorganisme si apa uzata, necesarul de oxigen, modul de utilizare a namolului biologic etc, fenomenele biochimice esentiale sunt identice.
Procesele de epurare biologica nu pot avea loc decat in cazul in care apele uzate supuse epurarii au valoare biologica, respectiv contin , pe o parte suficiente substante nutritive, iar pe de alta parte, dispun de substante necesare sintezei organice. Apele uzate menajere, prin natura lor, avand un continut complex de substante organice biodegradabile, intrunesc conditiile epurarii biologice.
Componenta organica a apelor uzate industriale variaza in functie de specificul industriei si materiilor prime prelucrate. Unele substante organice existente in apele uzate industriale sunt degradate cu usurinta de catre microorganisme, alte substante solicita, pentru indepartarea lor, o flora selectionata adaptata, iar alte substante sunt rezistente la atacul microorganismelor sau sunt degradate in timp indelungat.
Aceasta substanta organica din apele uzate, considerata globala, reprezinta substratul dezvoltarii microorganismelor.In momentul in care apa uzata intilneste o suprafata de contact, pe interfata dintre apa uzata si suprafata de contact se dezvolta colonii de bacterii si alte numeroase microorganisme. Aceste populatii mixte de bacterii, ciuperci si alte microorganisme ( in special protozoare si unele metazoare inferioare ) poarta denumirea de biomasa sistemului respectiv de epurare. Astfel la bazinele cu namol activat, biomasa se prezinta sub forma unor flocoane care plutesc in masa apei, fiind definita, calitativ si cantitativ, de namolul activat existent in bazin.
Indepartarea substantelor organice se face prin metabolism de catre o cultura mixta de microorganisme ( biomasa ), iar eficienta va fi maxima atunci cand sunt asigurate toate conditiile realizarii unei suprafete de contact cat mai mari ( epurarea biologica este un fenomen de suprafata ) si a mentinerii parametrilor favorabili desfasurarii procesului ( temperatura, alimentarea cu oxigen, incarcarea organica sau hidraulica etc ). Transferul de substante organice din apa uzata spre biomasa prin contact interfacial si prin fenomenul imediat urmator, de sorbtie ( adsorbtie si absorbtie ) va fi deci conditionat de marimea principalului parametru care este interfata apa uzata - biomasa ( este foarte important a se urmarii ca sa nu se formeze pelicule de apa pe aceasta interfata care va impiedica transferul de substante, in si din celulele microorganismelor, sau sa se acumuleze substante toxice. In bazinele cu namol activat suprafata flocoanelor este variabila in functie de mai multi factori. Marimea acestor suprafete este totusi foarte mare, ceea ce explica eficienta de epurare ridicata a bazinelor cu namol activ.
Schematic, procesul de epurare biologica se desfasoara astfel: substantele organice din apele uzate sunt adsorbite si concentrate la suprafata biomasei; aici, prin activitatea enzimelor eliberate de celula ( exoenzime ) substantele sunt descompuse in unitati mici care patrund celula microorganismelor unde sunt metabolizate; o parte a reactiilor de oxidare care au loc, furnizeaza energie reactiilor prin care se formeaza masa celulara noua, iar produsii finali ai descompunerilor ( produsi de oxidare ca H2O, CO2, azotati, sulfati, substante organice stabile etc ) sunt eliberati in mediu.
Rezulta ca prin epurarea biologica a apelor uzate, concomitent cu eliminarea substantei organice impurificatoare, se obtine cresterea biomasei sub forma materialului celular insolubil, sedimentabil, precum si produsi reziduali ( de metabolism sau din distrugerea celulelor ), unii usor de indepartat ( de ex. CO2 ), altii care raman dispersati in mediul lichid, conferind o anumita valoare a CCO-ului si CBO5-ului apei epurate.
Dezvoltarea biomasei, respectiv grosimea membranei biologice si volumul de flocoane , trebuie sa ramana intre anumite limite. Mentinerea biomasei in limite normale se realizeaza prin evacuarea ei din sistem. La bazinele cu namol activat cantitatea de biomasa necesara procesului poate fi reglata, ca fiind mare sau mai mica in functie de incarcarea organica a apelor uzate supuse epurarii. Biomasa suplimentara procesului este eliminata ( namol activ in exces ) fie spre rezolvarea unor necesitati tehnologice proprii (cresterea eficientei decantoarelor primare ) , fie spre stabilizarea finala in bazinele de fermentare a namolului.
Orientativ , cresterea biomasei, prin sinteza, se aproximeaza la 40-60 % din capacitatea de substanta organica, asimilabila, existenta in apa uzata menajera.
Pentru eliminarea substantelor organice din apele uzate brute, de la intrarea lor in statia de epurare, participa urmatoarele procese:
procese fizice ale transferului de masa ( separarea prin sedimentare a suspensiilor sedimentabile, a suspensiilor obtinute prin coagulare, ca si a materialului celular sedimentabil din apa epurata );
procese chimice ( reactii de hidratare, de hidroliza, de precipitare, modificari ale PH-ului etc );
procese biochimice ( reactii de asimilare sau reactii anabolice caracterizate prin cresterea materialului celular, reactii de oxidare sau reactii catabolice care conduc la obtinerea unor produsi finali inofensivi, inhibarea reactiilor enzimatice de catre substantele toxice etc );
procese hidraulice ( de curgere, timpi de retentie, viteze de sedimentare, incarcari hidraulice etc )
Desfasurarea fenomenelor biochimice caracterizate prin procese de asimilare sau de sinteza si prin procese de asimilare sau oxidare, este prezentata schematic in Fig. 1.
Fig.1. Schema proceselor generale de metabolism in epurarea aeroba .


Din Fig. 1, rezulta ca reactiile metabolice ale microorganismelor se desfasoara simultan prin cele doua laturi contradictorii si inseparabile : prin catabolism sau dezasimilatie, in care are loc degradarea ( oxidarea )substantelor organice, mai ales in scopul obtinerii energiei, si prin anabolism sau asimilatie, in care are loc sinteza materialului celular, folosind energia eliberata in reactiile de oxidare.
Mineralizarea substantelor organice ( transformarea elementelor ce le compun in oxizi : CO2, H2O, NO2 , NO3 , SO2 , PO4 etc ) se face prin consum de oxigen. Din aceasta cauza dupa cum s-a mentionat, substantele organice din apele uzate sunt de cele mai multe ori masurate si exprimate, cantitativ, prin cantitatea de oxigenceruta penru reactiile chimice si biochimice de oxigen ( CCO sau CBO5 )
Una din caracteristicile principale ale epurarii apelor uzate in instalatiile de epurare biologica este procesul de nitrificare, de consum al oxigenului pentru oxidarea formelor de azot trivalente ( NH3, NO2 ) la forma de valenta maxima, NO3 Acest proces se va aplica atunci cand se urmareste obtinerea unor ape epurate cu un continut minim de CBO5 impus de conditiile locale privind calitatea emisarului, sau cand se intentioneaza ca biomasa sa fie folosita ca fertilizator. Oxidarea substantelor organice cu continut de azot organic sau amoniac poate fi asa de avansata, incat efluentul sa contina cantitati apreciabile de nitrati si foarte putini nitriti, adica saruri cu continut mare de oxigen (NO3 ).Daca, de exemplu, substantele organice din apele uzate se prezinta sub forma de glucoza, iar azotul sub forma de amoniac, reactiile biochimice de oxido-reducere se prezinta sub forma :
transformarea substantelor organice dizolvate in material celular :
8(CH2O) + NH3 + 3O2 C5H7NO2 +3CO2 E ( 1.1 )
oxidarea substantelor organice acumulate sub forma de material celular :
C5H7NO2 + 5O2 5CO2 + NH3 + 2H2O ( 1.2 )
nitrificarea (oxidarea NH3) :
NH3 + 2O2 NHO3 + H2O )
Sub forma generala, ecuatiile biochimice pot fi scrise sub forma :
oxidarea materiei organice :
CXHYO2 + O2 CO2 + H2O E ( 1.4 )
sinteza materialului celular :
( CXHYO2) + NH3 + O2 celule + CO2 + H2 E )
oxidarea celulara :
celule + O2 CO2 + H2O +NH3 E ( 1.6 )
Reactiile de oxido-reducere a substantelor organice sunt reactii producatoare de energie fiind cuplate cu reactiile de sinteza a materialului celular nou ; aceste reactii nu pot fi despartite deoarece ultimele fiind endotermice, suma energiilor libere conducand la E negativ .
Despartirea fenomenelor, pe de o parte, in oxidare pe de alta parte tn sinteza, este facuta cu scop didactic. Reactiile de sinteza duc la formarea componentilor biochimici majori ( lipide, glucide, dar mai ales proteine ). Compozitia chimica a microorganismelor poate conduce, in conditii optime, la stabilirea unor formule empirice relativ constante.
Acestea pot fi forma : C5H7NO2 pentru bacterii, C10H17NO6 pentru fungi, C5H8NO2 sau C5,7H9,8NO2,3 pentru alge, C7H14NO3 pentru protozoare. Datorita predominantei cantitative a bacteriilor in biomasa, formula chimica, medie a acesteia este : ( C5H7NO2 )n.
Pentru obtinerea materialului celular nou, sunt necesare urmatoarele elemente esentiale :
C , H , O , N , S , P - in cantitati relativ mari,
K , Mg , Mn , Fe , CO , CU ,Zn ,MO - in cantitati mici.
Existenta acestor elemente in apele uzate exprima conditia minima necesara substratului, adica posibilitatea de tratabilitate biologica a apelor uzate, cu exceptia nitratilor si fosfatilor, cea mai mare parte a materialelor care intra in compozitia biomasei, sunt existente in apele uzate. Cerinta de azot si fosfor a microorganismelor este satisfacuta de apele uzate menajere si de cele ale unor industrii. Cerintele minime de azot si fosfor sunt exprimate in relatia :
CBO5 : N : P = 150 : 5 : 1 - pentru apa uzata si,
CBO5 : N : P = 90 : 5 : 1 - pentru namol
Cerinta elemente biogene de azot si fosfor duce la perturbari in ceea ce priveste activitatea biomasei, ceea ce impune, pentru apele lipsite de aceste elemente - cazul apelor industriale acestea sa fie introduse pe cale artificiala.
Microorganismele implicate in procesele aerobe necesita pentru metabolism ( ansamblu proceselor vitale de asimilare a unor substante din mediul inconjurator si de eliminare a produselor de dezasimilare in mediu ) oxigen. In mod normal, necesarul de oxigen este acoperit de oxigenul molecular dizolvat in apa, prezent tn proportie foarte mica (0,8% vol.) fata de cea din aer ( 21% vol. ). Aceasta face mediul acvatic foarte sensibil la nevoile de oxigen ale microorganismelor, in sensul ca poate deveni cu usurinta deficitar in oxigen.
Capacitatea de epurare a unei instalatii biologice depinde de masa microorganismelor (biomasa) pe care o contine. Ea este limitata de cantitatea de poluanti care poate fi asimilata de unitatea de biomasa in unitatea de timp. De aceea, cantitatea de poluanti organici aplicata in unitatea de timp unitatii de biomasa ( incarcare organica ) este la randul sau limitata.
2 ECOLOGIA PROCESULUI
In compozitia biomasei intra substanta organica vie, enzime, saruri minerale, amoniac, substante organice bio si nebiodegradabile, precum si substante organice aflate in diverse stadii de biodegrabilitate.
Luata in ansamblu, o instalatie de epurare biologica reprezinta un ecosistem cu trasaturi specifice. Prin ecosistem se intelege atat varietatea de organisme ce se grupeaza formand o biocenoza, cat si intregul complex de factori fizici si chimici in care acestea traiesc si se dezvolta, adica biotopul. Ecosistemul reprezinta, sub forma generala, un nivel de integrare a materiei intr-o unitate functionala alcatuita din doi componenti : unul anorganic ( biotopul ) si altul organic ( biocenoza ), fiecare component functionand pe baza informatiei primita de la celalalt. Intre ei exista o stransa interdependenta si un flux de materie si energie.
Unitatea functionala a instalatiilor de epurare biologica care exprima ecosistemul procesului va fi alcatuit din bazinul cu namol activat in care se afla apa uzata ( biotopul ) si flocoanele care alcatuiesc biocenoza.
Biocenoza din aceste instalatii se supune legitatilor existente in toate biocenozele naturale si anume :se formeaza spontan, se dezvolta si evolueaza selectand anumite conditii din mediul in care traieste si pe care il modifica. Instalatiile de epurare biologica artificiale, spre deosebire de cele naturale, constituie ecosisteme in care a intervanit omul, iar intensitatea procesului este dependenta de mecanismele reglabile de om. Pentru intelegerea si stapanirea procesului de epurare biologica este necesar a se cunoaste microorganismele care populeaza instalatiile de epurare , precum si caracteristicile si modul de viata a acestora.
In general, microorganismele care concura la procesul de epurare biologica, apartin regnului
" PROTISTA fiind alcatuite din : bacteria, ciuperci inferioare, alge, protozoare si metazoare. Aportul dominant in epurarea biologic il au bacteriile (peste 90 .
BACTERIILE sunt organism monocelulare care utilizeaza hrana solubila; fiecare celula este un organism independent, capabil sa execute toate functiile necesare vietii. Marimea celulei bacteriene variaza in timpul cresterii, avand limitele cuprinse intre 0,3 si 50μ; bacteriile comune din namolul active au limitele cuprinse intre 0,3 si 3μ (Mc Kynney, 1962 )si celula de diverse forme : sferica, cilindrica, spirala etc. Bacteriile sunt formate din 80% apa si 20% substanta uscata, din care 90% reprezinta substante organice. Fractia organica are compzitia medie de 50% C, 29% O, 12% N, si 6% H, ceea ce conduce la formula empirica aproximativa, C5H7NO2.
 In general structura celulei bacteriene cuprinde partile
component indicate in figura 2.1.
In general structura celulei bacteriene cuprinde partile
component indicate in figura 2.1.
Din punct de vedere al mediului in care traiesc, bacteriile din biocenoza (biomasa) sunt strict aerobe, deci folosind in mod necesar oxigenul dizolvat nu reprezinta o necessitate absoluta, ele fiind capabile de degradarea substantelor organice si in conditii de concenratii mai scazute de oxigen, sau chiar in conditii de anaerobie. Marea majoritate a bacteriilor sunt heterotrofe (saprofite), deci folosesc substante Fig.2.1-Structura celulei bacteriene
organice ca sursa de carbon si de energie. In biomasa instalatiilor de epurare biologic pot fi si bacteria autotrofe care sunt capabile sa-si formeze toate structurile celulare din substante anorganice , sursa de carbon fiind asigurata de CO2, de exemplu sulfobacterii, care oxideaza H2S la S sau la SO4 Nitrosomonas - Fig.2.2. si azotitul la azot, Nitrobacter - Fig.2.3.


Fig.2.2 - Nitromonas Fig.2.3 - Nitrobacter
Toate bacteriile autotrofe sunt strict aerobe. Cele mai multe tipuri de bacteria se inmultesc prin diviziunea transversala, binara, care comporta patru stadii :
a) diviziunea nucleara; b) alungirea celulara; c) diviziunea celulara; d) separarea celulara.
Transferul substantelor organice din mediul inconjurator in interiorul celulei bacteriene se face, la nivel de molecula, pe principiul presiunii osmotice.
Transferul direct este posibil atunci cand substanta organica din mediul acvatic este constituita din molecule mici (micromolecule care au pana la 6 atomi de carbon). In cazul in care substanta organica este contituita din molecule mai mari(macromoleculele continand mai mult de 6 atomi de carbon), celula bacteriana emite in exterior un tip de enzima(exoenzime) ce are rolul de a scinda macromoleculele in micromolecule, astfel incat, acestea sa poata trece prin membrana semipermeabila a celulei bacteriene.
Din punct de vedere al metabolismului energetic, deosebim bacterii fototrofe (energia provine din radiatia solara), si bacterii chemotrofe (energia provine din descompunerea compusilor chimici organici sau anorganici) in cadrul reactiilor biochimice de oxidare. In procesul de oxidare (dezasimilatie), energia solara poate fi utilizata numai de bacteriile fototrofe(fotosintetice).
Reactiile biochimice de oxido-reducere pot fi de mai multe feluri :
respiratie aeroba, cand pentru oxidarea substantelor organice se foloseste O2 din aer ;
respiratie anaeroba, cand O2 este luat din diversi compusi ca: HNO3, H2SO4, H2CO3 ;
fermentare, cand substanta organica este in acelasi timp si oxidant si oxidat.
Cand energia este obtinuta pe calea respiratiei aerobe, transformarea nutrientilor (substante organice) in material celular este de 60%, iar cand este obtinuta pe calea fermentarii este de numai 5%. Dupa aspectul morfologic bacteriile intalnite in apele uzate se impart in patru grupe si anume :
a) Bacteriile libere - sunt prezente permanent in masa namolului activat , din bazinele de aerare care prin procesul de aerare au tendinta de a se aglomera in flocoane. Numarul si tipurile bacteriilor libere, reprezinta unul din indicatorii cei mai rapizi si sensibili ai gradului de stabilitate a biocenozelor bazinelor de namol activat. Printre bacteriile libere din apele uzate intalnim :
Cocii - Coccus (Micrococcus) - Fig.2.4, Streptococcus, Staphylococcus, Diplococcus , Tetracoccus., Sarcina ;
Bacterii libere sub forma de bastonase lungi - Bacterium, Bacillus, Diplobacterium, Streptobacterium.
Vibrioni si Spirili - Vibrio si Spirillum - Fig.2.5,

Fig.2.4 - Coccus Fig.2.5 - Spirillum
 b)Bacterii
in ingramadiri - au
rolul cel mai important in degradarea substantelor organice. In
conditii normale bacteriile in ingramadiri constituie grupul
dominant in procesul de epurare, reprezentand adesea 90% din masa
namolului activat. S-a constatat experimental ca exista un
paralelism intre modificarile suferite in timp de aceste bacterii si
valorile eficentei de epurare, exprimata in reducerea CBO5,
deci modificarile suferite in timp de bacteriile in ingramadiri
intr-o instalatie, reflecta cel mai bine mersul general al
epurarii apelor uzate. Printre bacteriile in ingraradiri mai
importante amintim :
b)Bacterii
in ingramadiri - au
rolul cel mai important in degradarea substantelor organice. In
conditii normale bacteriile in ingramadiri constituie grupul
dominant in procesul de epurare, reprezentand adesea 90% din masa
namolului activat. S-a constatat experimental ca exista un
paralelism intre modificarile suferite in timp de aceste bacterii si
valorile eficentei de epurare, exprimata in reducerea CBO5,
deci modificarile suferite in timp de bacteriile in ingramadiri
intr-o instalatie, reflecta cel mai bine mersul general al
epurarii apelor uzate. Printre bacteriile in ingraradiri mai
importante amintim :
Genul Pseudonomas - Fig.2.6 - cea mai bogata flora bacteriana mai ales sub aspect calitativ, sunt mai prezente in namolul activ menajer, datorita compozitiei apelor uzate in substante organice nutritive si in factori de crestere. Genul Pseudonomas ocupa un loc predominant printre bacteriile din namolul activ.
Fig.2.6 - Genul Pseudonudmas
Bacterium
Sarcina - Fig 2.7
Zooglea- Fig 2.8


Fig.2.7 - Sarcina Fig.2.8 - Zooglea
c) Bacteriil in formatiuni, cele mai semnificative sunt bacterii zoogleale - Fig.2.6 care apar mai ales in cazul incarcarilor organice mari unde se inregistreaza, la inceput, deficit de oxigen. Privita la microscop biomasa care contine aceste formatii zoogleale, apare dezlanata, lichidul este plin de bacterii libere, iar cele in ingramadiri sunt putine si predomina unele bacterii filamentoase care determina umflarea namolului. Sunt formatiuni zoogleale subtiri, care apar la incarcari organice mari ; formatiuni zoogleale lobate, care apar la deficit de oxigen ; formatiuni zoogleale hemisferice si sferice care apar la cresterea brusca a incarcarii organice.
d) Bacterii filamentoase prezinta o componenta frecventa a flocoanelor de namol activat. Dezvoltarea excesiva a acestor bacterii formeaza o retea deasa de ochiuri in interiorul careia apa si aerul circula cu mare greutate ajungandu-se la o carenta de hrana si de oxigen care dauneaza si celorlalte microorganisme, cauzandu-le disparitia. Cand domina bacteriile filamentoase, eficienta de epurare exprimata in CCO si CBO5, este scazuta, iar biomasa nu decanteaza in clarificatorul final, se manifesta tendinta de plutire a namolului activ in decantoarele secundare. In namolul activ intalnim urmatoarele bacterii filamentoase : Sphaerotilus Natans - Fig 2.9 si Beggiatoa Alba - Fig.2.10.


Fig.2.9 - Sphaerotilus Natans Fig.2.10 - Beggiatoa Alba
In epurare apelor uzate industriale, flora bacteriana a diferitelor namoluri active variaza calitativ si cantitativ. Astfel, apele industriale cu un continut bogat de proteine favorizeaza dezvoltarea genurilor Alcaligenes, Flavobacterium si Bacillus, iar continutul in glucide favorizeaza dezvoltarea genului Pseudonomas ; acizi grasi , aldehide, acetone si alcooli stimuleaza dezvoltarea genurilor Pseudonomas, Micrococcus, Bacillus, Achromobacter.
CIUPERCILE sunt organisme nefotosintetice care absorb hrana, ce bacteriile, in stare dizovata. Ele joaca de obicei un rol secundar in epurarea apelor uzate, putand degrada substante organice de naturi diferite ca : celuloza, fenoli, hidrocarburi etc. S-a constatat ca interventia ciupercilor in procesul de epurare biologica este cauzata de concentratia scazuta de oxigen provocata de incarcarea organica excesiva din apele uzate, de valoarea scazuta a pH-ului (sub 7) si de cantitatea scazuta de azot. Cand cipercile se inmultesc mult apare fenomenul de umflare a namolului activat, ceea ce indica o slaba decantare si o eficienta redusa a procesului de epurare biologica cauzata si de distrugerea florei bacteriene.
Formele cele mai comune de ciuperci izolate din probe de namol activ sunt :
-Aspergillus - Fig.2.11, Mucor - Fig.2.12, Penicillium, Candida, Rhizopus, Sepedonium, Fusarium, Sporotrichum, Sacchromyces etc.


Fig.2.11 - Aspergillus Fig.2.12 - Mucor
PROTOZOARELE constituie un component aproape obligatoriu al biomasei. Fiind organisme predatoare, contribuie la epurarea apelor uzate prin mentinerea unui echilibru in dezvoltarea bacteriilor, mai ales al celor libere, jucand un rol de seama in limpezirea apelor epurate. Sunt deci cele mai bune indicatoarte ale modului in care functioneaza un namol activ. Protozoarele sunt strict aerobe si majoritatea ingereaza hrana ca particule solide, dar se pot hrani si prin difuzia in celula a substantelor organice dizolvate, daca acestea sunt in concentratie mare, de 5-10 g/dm3; exceptie fac flagelatele care pot metaboliza si substante organice in concentratii reduse. Multe protozoare nu isi pot sintetiza toate substantele necesare cresterii si depind de bacterii in furnizarea acestor produsi. Formula empirica a protoplasmei protozoarelor este C7H14NO3. Dintre ele, mai importante in procesul de epurare sunt: Rhizopodele, Flagelatele si Ciliatele.
Rhizopodele care domina foarte rar si numai in sistemele care pornesc corect, sau care si-au revenit de nla un grad mai mare de intoxicare.
Cateva forme de rhizopode intalnite in namolul activ sunt: Amoeba Proteus - Fig.2.13, Amoeba Verrucosa, Arcella Vulgaris - Fig.2.14, Astramoeba Radiosa, Vahlkampfia Limax Centropyxis Acuelata, Difflugia Urceolata, Nebela Collaris, Hyalosphenia Papilio, Trinema Enchelys, Actinophrys Sol, Actinosphaerium Eichorni etc.


Fig.2.13 - Amoeba proteus Fig.2.14 - Arcella Vulgaris
Flagelatele apar in numar mare in primele zile dupa punerea in functiune a instalatiilor sau dupa o intoxicare grava, la refacerea biocenozei. Flagelatele se inmultesc si pier cu mare repeziciune si se inmultesc mai ales in momentele de instabilitate accentuata a echilibrului dinamic al biocenozei. Sunt de doua feluri:
 a) Fitoflagelatele - exista numai atunci cand substantele
organice sunt intr-o concentratie mare. Fitoflagelatele inica faptul
ca efluentul continua sa aiba multe substante
organice. Dintre fitoflageletele care traiesc in namolul activ avem: Chrysamoeba, Chromulina, Chilomonas-Fig.2.15, Cryptomonas, Polytoma, Euglena Virdis - Fig2.16,
Hexamitus, Peronema, Gymnodinium, Notosolenus, Heteronema, Carteria, Chlamydomonas etc.
a) Fitoflagelatele - exista numai atunci cand substantele
organice sunt intr-o concentratie mare. Fitoflagelatele inica faptul
ca efluentul continua sa aiba multe substante
organice. Dintre fitoflageletele care traiesc in namolul activ avem: Chrysamoeba, Chromulina, Chilomonas-Fig.2.15, Cryptomonas, Polytoma, Euglena Virdis - Fig2.16,
Hexamitus, Peronema, Gymnodinium, Notosolenus, Heteronema, Carteria, Chlamydomonas etc.

Fig.2.15 - Chilomonas Fig.2.16 - Euglena virdis
b) 
 Zooflagelatele- apar dupa disparitia fitoflagelatelor,
acestea indica un sistem mai eficient de epurare al apelor uzate, decat
precedentele. Cateva forme de zooflagelate intalnite in namolul activat
sunt : Bodo Caudatus, Bodo Edax, Bodo
Putrinus, Cerbodo Longicauda - Fig.2.17, Bikosoeca, Codonosiga, Monosiga - Fig.2.18,
Oicomonas Socialis etc.
Zooflagelatele- apar dupa disparitia fitoflagelatelor,
acestea indica un sistem mai eficient de epurare al apelor uzate, decat
precedentele. Cateva forme de zooflagelate intalnite in namolul activat
sunt : Bodo Caudatus, Bodo Edax, Bodo
Putrinus, Cerbodo Longicauda - Fig.2.17, Bikosoeca, Codonosiga, Monosiga - Fig.2.18,
Oicomonas Socialis etc.
Fig.2.17 - Cerbodo Longicauda Fig.2.18 - Monosiga
Ciliatele au un rol foarte important in procesele de epurare, prezenta lor indicand o stare generala de functionare buna a intregii epurari, mentinand un echilibru in dezvoltarea bacteriilor, mai ales a celor libere. Un singur ciliat poate ingera intre 20.000 si 40.000 bacterii / ora. Aparitia si inmultirea ciliatelor libere are loc dupa ce in instalatii s-au format flocoanele bacteriene si rhizopodele si flagelatele au avut o dezvoltare maxima. Ciliatele se gasesc in namolul activ in doua stari, libere si fixe :
a) Ciliatele libere sunt foarte cosmopolite, nici o specie nu este caracteristica instalatiilor de epurare, totusi sunt unele forme, inicatoare eficientei epurarii apelor uzate, obtinut in treapta biologica. Sunt ciliate libere indicatoare unei epurari bune printe cele mai semnificative fiind: Aspidisca Lyceus - Fig 2.19 ,Aspidisca Costata, Paramecium Putrinum, Paramecium Bursaria, Liotonus Fascicola, Euplotes Charon , Didinium Nastusum - Fig 2.20 etc.


Fig.2.19 - Aspidisca Lyceus Fig.2.20 - Didinum Nastusum
Sunt si ciliate libere indicatoare ale unei epurari slabe a apelor uzate : Colpidium Colpoda - Fig.2.21, Metopus Es , Glaucoma Scintillans, Tetramhymena Pyriformis - Fig.2.22 etc.


Fig.2.21 - Colpidium Colpoda Fig.2.22 - Tetrahymena Pyriformis
b) Ciliatele fixe apar in urma inmultirii ciliatelor libere marcand atingerea eficientei ridicate da epurare a apelor uzate, si stabilizarea biocenozei. Ele indica practice o epurare avansata a apelor uzate. Avem doua tipuri de ciliate fixe si anume : ciliate filtratoare dintre care amintim- Vorticella Microstoma, Vorticella Convallaria - Fig.2.23, Vorticella Silimis, Carchesium Polypinum, Opercularia Articulata etc., si ciliate rapitoare - suctorii - care se intalnesc mai rar in bazinele de aerare si aproape intotdeauna in exemplare izolate si sunt prezenti mai ales in instalatiile care lucreaza cu durate mari de aerare. Dintre acestia amintim : Acineta Grandis - Fig.2.24, Tocophrya Cyclopum, Tocophrya Infusionum, Podophrya Fixa, Sphaerophrys Sol etc.


Fig.2.23 - Vorticella Convallaria Fig.2.24 - Acineta Grandis
 METAZOARELE sunt reprezentate in biomasa prin putine grupe
si anume : rotiferi - Rotifer
Vulgaris - Fig.2.25, Rotaria Rotatoria,Cephalodella Sterea, Lecane Clara etc., nematode - Diplogaster - Fig.2.26
si crustacei. Rotiferii apar numai in namolurile active cu
capacitate mare de stabilizare a apelor uzate, deci in mediu cu
continut scazut de substante organice. Sunt
organism strict aerobe, avand ca principal sursa de hrana bacteria
si particule organice.
METAZOARELE sunt reprezentate in biomasa prin putine grupe
si anume : rotiferi - Rotifer
Vulgaris - Fig.2.25, Rotaria Rotatoria,Cephalodella Sterea, Lecane Clara etc., nematode - Diplogaster - Fig.2.26
si crustacei. Rotiferii apar numai in namolurile active cu
capacitate mare de stabilizare a apelor uzate, deci in mediu cu
continut scazut de substante organice. Sunt
organism strict aerobe, avand ca principal sursa de hrana bacteria
si particule organice.

Fig.2.25 - Rotifer Vulgaris Fig.2.26 - Diplogaster
Intre microorganismele care alcatuiesc biomasa instalatiilor de epurare biologica exista interrelatii, dintre care o insemnatate mare o au relatiile trofice(de hrana). In biomasa producatorii de substanta organica vie sunt in special bacteriile, care formeaza protoplasma prin degradarea diferitelor substante organice dizolvate in apele uzate, consumatorii producatorilor sunt protozoarele si metazoarele. Protozoarele bacterivore, mai ales ciliatele libere si fixe, reprezinta consumatori primari; acestia servesc ca hrana consumatorilor secundari (rotiferi, nematode, suctori etc).
In concluzie, bazinele de namol activat prezinta un mediu acvatic relativ uniform, flocoanele fiind antrenate de curentul de apa, sunt raspandite uniform in bazin si contin, in general, microorganism de acelasi fel. Organismele din grupa metazoarelor sunt foarte rare. Aici bacteriile sunt principalii agenti ai epurarii, iar protozoarele indica modul cum decurge aceasta epurare. Indicatiile asupra modului de functionare a instalatiei dau flocoanele de namol activat. Cu cat cresc in marime, suprafata de contact este redusa in raport cu volumul lor, iar pe de alta parte, difuzia hranei in interiorul floconului, respectiv eliminarea substantei organice degradate, se face mai greu. Varsta flocoanelor definita de continutul de flocoane in recirculare si de cele noi formate intr-un anumit interval de timp, determina eficienta epurarii apelor uzate. Cu cat varsta este mei mare, cu atat creste proportia de celule moarte in detrimentul celor active. Echilibrul dintre reactiile de oxidare a substratului si de sinteza a materialului celular nou poate conduce la indepartarea, in procente foarte ridicate, de 85 - 90% a materiilor organice.Viteza de indepartare a substratului este conditionata de viteza de dezvoltare a biomasei, care la randul ei depinde de urmatorii factori :
compozitia biologic a biomasei;
sursa de hrana(calitatea si concentratia substratului);
factorii de mediu(temperatura, oxigenul dizolvat etc).
3 NAMOLUL ACTIVAT. CALITATILE BIOLOGICE, FIZICE SI CHIMICE ALE NAMOLULUI ACTIVAT.
Asupra calitatilor biologice ale namolului activat s-au prezentat in detaliu , in subcapitolul 2 care sunt microorganismele care participa la procesul de epurare biologica. Incarcarea unei instalatii biologice poate fi recunoscuta dupa bioceniza existenta. Instalatiile de mare incarcare au o biocenoza in care domina bacteriile de genul Zooglea (ciliatele sunt in numar redus). In aceste instalatii hrana necesara microorganismelor este suficienta pentru a evita autooxidarea, prin care o parte din namolul activat este mineralizat. Asemenea instalatii sunt caracterizate de randamente mari de epurare, insa necesita un consum ridicat de energie. La instalatiile biologice de mica incarcare organica, creste numarul ciliatelor, care, prin distrugerea bacteriilor libere, nelegate de colonii, participa la imbunatatirea calitatii apei epurate sub aspectul eliminarii unei cantitati suplimentare de CBO5, ca urmare a eliminarii bacteriilor libere provenite din procesul de autooxidare(faza endogena). Calitatile fizice ale namolului activ caracterizeaza modul de alcatuire al flocoanelor de namol activat, cu referire asupra concentratiei de Materii Totale in Suspensie (MTS) care influenteaza procesul de epurare. In aceeasi masura, este important procesul de sedimentare maxima al flocoanelor in decantorul secundar. O buna floculare a namolului, exprimata printr-o concentratie mai ridicata a MTS-ului, combinata cu o buna decantare a namolului activat sunt conditiile necesare realizarii unei eficiente ridicate a epurarii biologice.
Aceste insusiri ale namolului activat sunt puse in evidenta de Indicele Volumetric al Namolului (IVN) numit si Index Mohlmann. Acest indice se defineste ca volumul unui gram de materii totale in suspensie, considerat la umiditatea corespunzatoare si determinat dupa un timp de 30 minute de sedimentare conform relatiei
IVN = Sediment la 30 min/ 1 gr de namol activ cm3/g
Procesul de epurare dintr-un bazin cu namol activat se desfasoara in conditii de eficienta maxima daca IVN = 50-150 cm3/g ; la o crestere a Indicelui Mohlmann peste 200 cm3/g se poate vorbi despre un namol infoiat (bolnav), cu proprietati de decantare exterem de reduse, cauza formarii acestui namol usor, care pluteste la suprafata apei din decantorul secundar, o constituie dezvoltarea, cu preponderenta, a bacteriilor filamentoase si a fungilor. Pe baza urmaririi continue a valorii Indicelui Mohlmann, cu o aparatura corespunzatoare, se asigura o recirculare dinamica a namolului activat din decantorul secundar. Literatura de specialitate si cercetarile recente indica existenta unei stranse interdependente dintre Indicele Volumetric al Namolului si Incarcarea Organica a Namolului Activ (ION) . Acest ultim indicator al namolului activ constituie un parametru important deoarece exprima cantitatea totala de substanta organica , exprimata in kilograme consum biochimic de oxigen,( kg CBO5), aferenta, in decurs de o zi, unui kilogram din Fractiunea Volatila a Namolului Activat (NV).
La bazinele cu namol activat se poate admite o zona critica a incarcarii organice stabilite intre valorile de 0,3- 1,5 kg CBO5/kg NV zi, aceasta gama de incarcari vor conduce la eficiente de epurare in limite destul de avansate, de 83% pana la 90%.
Un alt indicator fizic al namolului activ il constituie Procentul de Materii Totale in Suspensii(MTS) separabile prin decantare, sau raportul, in procente dintre volumul de namolrezultat din decantarea timp de 30 minute a amestecului din bazinul de aerare, intr-un cilindru , Con Imhoff, de 1 dm3 umplut pana la acest reper. Acest raport variaza intre 10-25% cu medie de 12%, volumul de namol activ depus reprezentand 100-250 ml/dm3.
Calitatile chimice ale namolului activ exprima continutul Azotului Organic din albuminele care intra in componenta organismelor vii. Continutul in Azot Organic este apreciat la circa 4-8% din valoarea Materiilor Totale in Suspensie (MTS). Un continut mai scazut in azot organic inseamna o incarcare ridicata a flocoanelor cu substante anorganice, deci o activitate biochimica redusa.
|
Politica de confidentialitate | Termeni si conditii de utilizare |

Vizualizari: 9053
Importanta: ![]()
Termeni si conditii de utilizare | Contact
© SCRIGROUP 2025 . All rights reserved